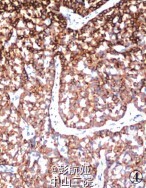

患者,62 岁,因发现右乳肿物 1 年,腹痛、腹胀 20 天伴血便入院。 查体:乳腺右侧外上象限触及一直径约 4 cm 肿物,质硬,活动,与周围界较清;左侧盆腔包块,直径约 11 cm。影像学检查:钼靶显示右乳腺浅分叶状高密度影,边界尚清,无钙化及毛刺征;CT 平扫盆腔类圆形实性肿块影,边界清晰,瘤体内见不定形钙化,结肠部分肠腔狭窄,肠壁增厚;遂行结肠镜检查示乙状结肠可见肿物,覆脓苔,质脆。 血清中 CEA 70. 23μg/ ml、CA125 422.15 KU/ L,CA199 137.53 U/ml。 遂行右乳肿物切除术 + 乙状结肠癌切除术及左侧附件切除术。 术中所见:右乳肿物分叶状,与周围界清;乙状结肠肿物与周围无粘连;左侧卵巢肿物包膜完整,未见腹水。 术后病理显示右乳腺内分泌癌,乙状结肠腺癌,左侧卵巢 Brenner 瘤。病理检查摇 眼观:右乳肿物 1 个,大小 3.5 cm *3 cm *2cm,无明确包膜,分叶状,切面灰白,质脆;结肠见一溃疡性肿物,大小 3. 5 cm *3 cm *1. 5 cm,切面灰白色,质脆,侵及全层;左侧卵巢肿物 1 个,大小 8 cm *6.5 cm*5 cm,包膜完整,切面淡黄色,质韧。 镜检:乳腺肿瘤由密集排列的细胞巢 组成,被纤细的纤维血管间质分隔,部分细胞呈短梭形,部分呈浆细胞样,可见菊形团结构(图 1);(结肠)肠壁间及浆膜下脂肪组织可见大部分癌组织排列成腺腔样,小部分呈片状分布,细胞核深染,异型明显,间质纤维化明显(图 2);卵巢肿瘤纤维瘤样间质中见巢状、岛状的移行细胞,瘤细胞呈咖 啡豆样,有纵行核沟,胞质丰富,嗜酸性,部分细胞巢中央有空腔(图 3)。 免疫表型:乳腺肿瘤 CgA(图 4)、NSE、CK、ER和 PR 均( + ),60% 细胞 Syn(图 5)( + ),HerbB-2、CA125 均( - );卵巢肿瘤 CK7、CK5/6 均( + ),Ki-67( - )。病理诊断:右乳神经内分泌癌;结肠腺癌;左侧卵巢Brenner 瘤。